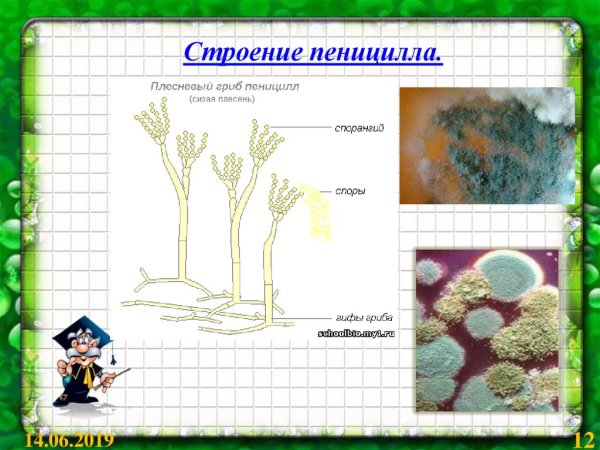
Части плесневого гриба пеницилла

Пеницилл – это растение семейства зонтичных, которое привлекает внимание своим уникальным рисунком на листьях. Характерной особенностью пеницилла является его причудливый узор, напоминающий абстрактные линии и формы. Этот рисунок делает растение неповторимым и привлекательным для любителей экзотических растений и коллекционеров. Листья пеницилла часто использовались в декоративных композициях и букетах благодаря своему необычному внешнему виду. Кроме того, пеницилл обладает целебными свойствами и используется в медицине как природный антибиотик. Благодаря своей эстетической привлекательности и полезным свойствам, пеницилл пользуется популярностью среди цветоводов и заботливых садовников.
Плесневые грибы пеницилл
Конидии пеницилла
Спорангии пеницилла
Плесневый гриб пеницилл
Конидиеносец пеницилла
Плесневый гриб пеницилл строение
Плесневые грибы пеницилл
Пенициллин гриб строение
Строение грибницы пеницилла
Пенициллин гриб строение
Плесневый гриб пеницилл строение
Конидии пеницилла
Строение плесневого гриба пенициллина
Пеницилл строение гриба ЕГЭ
Penicillium микробиология
Пенициллин гриб строение
Гриб пеницилл строение
Части плесневого гриба пеницилла
Строение плесени пеницилл
Пенициллин рисунок
Таблица мукор пеницилл дрожжи
Строение плесневого гриба пеницилла
Пеницилл строение рисунок
Пенициллин и мукор
Строение мицелия Penicillium
Конидиеносец Aspergillus
Пенициллин гриб строение
Пеницилл сапрофит
Мукор пеницилл аспергилл
Гриб пеницилл
Части плесневого гриба пеницилла
Пеницилл и аспергилл
Строение пеницилла и строение мукора
Конидии пеницилла
Пеницилл гриб паразит
Конидиеносец Aspergillus
Спорангии пеницилла
Пеницилл циклопический
Пеницилл клеточное строение
Строение мицелия пеницилла
Конидии пеницилла
Плесневые грибы строение
Пеницилл строение
Плесневые грибы строение размножение
Сизая плесень пеницилл
Мицелий пеницилла Penicillium
Пеницилл строение микробиология
Смотрите онлайн или можете скачать на телефон или компьютер в хорошем качестве совешенно бесплатно. Не забывайте оставить комментарий и посмотреть другие фотографии и изображения высокого качества, например единорожка рисунок и гроза рисунок из раздела Рисунки

Grizly.club
Grizly.club